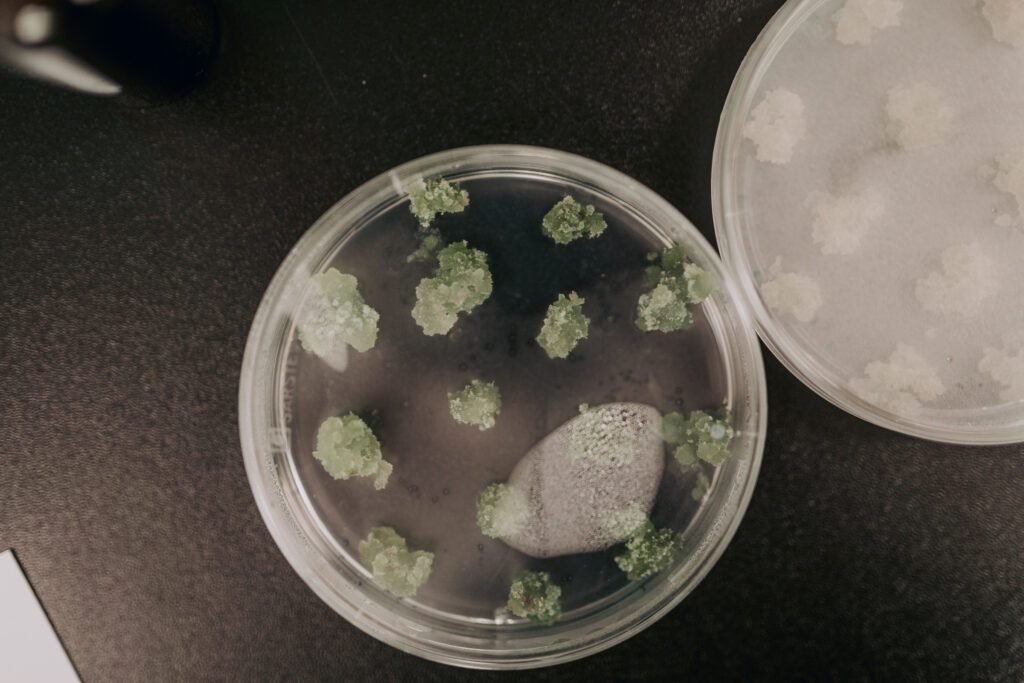

Vidzemes reģions uzsācis ceļu pretī zināšanās balstītas bioekonomikas inovāciju sistēmas attīstīšanai reģionā, tāpēc Vidzemes plānošanas reģions un Vides risinājumu institūts martā organizēja starptautisku bioekonomikas inovāciju forumu Cēsīs, pulcējot vairāk nekā 100 dalībnieku no Latvijas un ārvalstīm.
Bioekonomika ir atjaunojamo dabas resursu izmantošana produktos un pakalpojumos, ar ko var aizstāt tos resursus, kas dabā neatjaunojas un kas pamazām izsīkst. Lai arī tā ir cieši saistīta ar klimata pārmaiņu radīto apdraudējumu, tomēr vienlaikus tā skatāma arī kā pavisam jauns ekonomikas virziens.
Latvijā bioekonomika ir nacionāli definēta kā viena no viedās specializācijas jomām. Arī Vidzemes reģionā tā identificēta kā joma, kurai nepārprotami saskatāms reģiona attīstības izaugsmes potenciāls, tāpēc bioekonomikai reģiona attīstībā šobrīd piešķirta virzītājspēka loma.
Vidzemes reģionā ir apjomīgs meža resurss, tomēr jāatceras, ka bioekonomika aptver daudz plašāku jomu klāstu – gan pārtikas ražošanas, gan lauksaimniecības sektoru, arī tādas nozares kā mežsaimniecība un kokrūpniecība, ķīmijas un farmācijas rūpniecību, enerģētiku un energoefektivitāti, būvniecību, informācijas un komunikāciju tehnoloģijas (IKT) veselības nozari u.c.
Lene Lange, pētniecības un konsultāciju uzņēmuma “LLA-Bioeconomy” vadītāja un Ziemeļvalstu bioekonomikas paneļa biedre (Dānija), lektore arī Vidzemes bioekonomikas forumā uzsver: “Pārtikas pārstrādes un ražošanas procesā ir ļoti liels blakus produktu apjoms. Tie netiek izmantoti, bet potenciāls ir neiedomājami liels. Iegūstamie produkti ir ne vien ar augstu uzturvērtību, bet arī ar lielu garšas potenciālu”.
Foto: Slieku izmantošanas iespējas pārtikā
Bioekonomikas forumā Cēsīs ar savu 25 gadu pieredzi mežsaimniecībā dalījās Arne Rørå – “Norskog Group” izpilddirektors. A. Rørå bijis atbildīgs par Norvēģijas nacionālo meža inventarizāciju un pārstāvējis Norvēģiju vairākās starptautiskās programmās, kas saistītas ar meža inventarizāciju un gaisa piesārņojuma ietekmes uz mežu uzraudzību. Eksperts Latvijā bieži viesojas kopš 2001. gada un secinājis, ka šeit meža potenciāls netiek izmantots pilnībā.
Arne Rørå norāda: “Latvijā ir ļoti augstvērtīga augsne. Novērojumi liecina, ka Latvijas Valsts meži lieliski tiek galā ar mežu apsaimniekošanu, kamēr privātajā sektorā būtu jāvairo zināšanas un jāinformē par iespējām, kā to veikt efektīvāk, vienlaikus iegūstot lielāku pievienoto vērtību no resursa. Latvijā joprojām meži ir pārāk skraji un ir daudz platību, kas aizaugušas krūmiem – tā ir resursa izniekošana.“ Eksperts zina teikt, ka ar vienu eiro, kas investēts mežā, ieguldījums vērtību ķēdē atmaksājas 10 reizes, vienlaikus atgādinot, ka nekādā ziņā nedrīkst aizmirst par dabas aizsardzību.
Lene Rachel Andersen, ekonomikas eksperte un futūriste no Dānijas ir pārliecināta: “Lai spētu nodrošināt dabas un vides ilgtspējību, vispirms ir jāmaina domāšanas veids, jo pagaidām vēl domājam no industriālās paradigmas skatupunkta – jo lētāk, jo labāk. Ir laiks paplašināt redzesloku.”
Jāpiebilst, ka drīzumā tiks uzsākts arī video lekciju publicēšanas cikls, piedāvājot iespēju foruma dalībniekiem atkārtoti noskatīties ekspertu uzstāšanos, kā arī vienlaikus aicinot citus interesentus, kas nebija klāt pasākuma norises vietā, smelties iedvesmu un padomus bioekonomikas principu iedzīvināšanai savā ikdienā.
Tāpat pasākuma organizatori apstiprina, ka bioekonomikas inovāciju attīstīšanai veltīti izzinoši un iedvesmojoši pasākumi Vidzemē tiks rīkoti arī turpmāk, no kuriem tuvākais plānots 2019. gada rudenī.
Papildinformācijai par projektu
Projektu “Bioekonomikas inovāciju sistēmas attīstīšana reģionos (RDI2CluB)” īsteno Vidzemes plānošanas reģions sadarbībā ar nodibinājumu „Vides risinājumu institūts”, kā arī partneri no Norvēģijas, Somijas, Igaunijas un Polijas Interreg Baltijas jūras reģiona (BJR) programmas 2014.-2020. gadam ietvaros (http://www.rdi2club.eu/), ar Eiropas Reģionālās attīstības fonda un Norvēģijas līdzfinansējumu. Tā mērķis ir atbalstīt viedu, ilgtspējīgu un iekļaujošu bioekonomikas nozares izaugsmi BJR lauku teritorijās. Šī informācija atspoguļo vienīgi autora uzskatus, un Eiropas Savienība nav atbildīga par tajā ietvertās informācijas iespējamo izmantošanu.
Foto: Roberts Āboltiņš
Papildu informācija: Santa Niedola, projekta “RDI2CluB” vadītāja Vidzemes plānošanas reģionā, santa.niedola@vidzeme.lv, +371 26674261, www.vidzeme.lv
Informāciju sagatavoja: Anita Āboliņa, sabiedrisko attiecību vadītāja Vidzemes plānošanas reģionā, anita.abolina@vidzeme.lv, +371 29454752